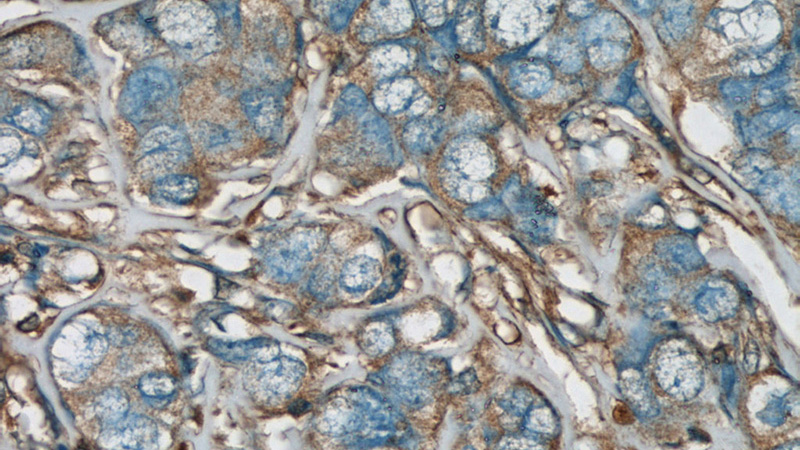
Immunohistochemical of paraffin-embedded human breast cancer using Catalog No:114663(ARHGDIA,aGDI antibody) at dilution of 1:50 (under 40x lens)

-
Product Name
RhoGDI antibody
- Documents
-
Description
RhoGDI Rabbit Polyclonal antibody. Positive WB detected in Jurkat cells, A431 cells, HEK-293 cells, HeLa cells, HL-60 cells, mouse pancreas tissue. Positive IHC detected in human breast cancer tissue, human colon cancer tissue. Observed molecular weight by Western-blot: 28 kDa
-
Tested applications
ELISA, WB, IHC
-
Species reactivity
Human,Mouse,Rat; other species not tested.
-
Alternative names
aGDI antibody; ARHGDIA antibody; GDIA1 antibody; Rho GDI 1 antibody; Rho GDI alpha antibody; RHOGDI antibody; RHOGDI 1 antibody
-
Isotype
Rabbit IgG
-
Preparation
This antibody was obtained by immunization of RhoGDI recombinant protein (Accession Number: NM_004309). Purification method: Protein A purified.
-
Clonality
Polyclonal
-
Formulation
PBS with 0.1% sodium azide and 50% glycerol pH 7.3.
-
Storage instructions
Store at -20℃. DO NOT ALIQUOT
-
Applications
Recommended Dilution:
WB: 1:500-1:5000
IHC: 1:20-1:200
-
Validations

Jurkat cells were subjected to SDS PAGE followed by western blot with Catalog No:114663(ARHGDIA,aGDI antibody) at dilution of 1:1000

Immunohistochemical of paraffin-embedded human breast cancer using Catalog No:114663(ARHGDIA,aGDI antibody) at dilution of 1:50 (under 10x lens)
Immunohistochemical of paraffin-embedded human breast cancer using Catalog No:114663(ARHGDIA,aGDI antibody) at dilution of 1:50 (under 40x lens)
-
Background
Aplysia Ras-related homologs (ARHs), also called Rho genes, belong to the RAS gene superfamily encoding small guanine nucleotide exchange (GTP/GDP) factors. The ARH proteins may be kept in the inactive, GDP-bound state by interaction with GDP dissociation inhibitors, such as ARHGDIA (also called Rho GDP-dissociation inhibitor 1, Rho GDI1). Rho GDI1 acts as a metastasis-related protein in colon and prostate cancer patients and may be useful as a diagnostic biomarker to prevent colon and prostate cancer metastasis.
-
References
- Song Q, Xu Y, Yang C. miR-483-5p promotes invasion and metastasis of lung adenocarcinoma by targeting RhoGDI1 and ALCAM. Cancer research. 74(11):3031-42. 2014.
- Liu C, Lin JJ, Yang ZY, Tsai CC, Hsu JL, Wu YJ. Proteomic study reveals a co-occurrence of gallic acid-induced apoptosis and glycolysis in B16F10 melanoma cells. Journal of agricultural and food chemistry. 62(48):11672-80. 2014.
- Zeng Z, Bo H, Gong Z. AFAP1-AS1, a long noncoding RNA upregulated in lung cancer and promotes invasion and metastasis. Tumour biology : the journal of the International Society for Oncodevelopmental Biology and Medicine. 2015.
- Bo H, Gong Z, Zhang W. Upregulated long non-coding RNA AFAP1-AS1 expression is associated with progression and poor prognosis of nasopharyngeal carcinoma. Oncotarget. 6(24):20404-18. 2015.
- Lichtenfels R, Mougiakakos D, Johansson CC. Comparative expression profiling of distinct T cell subsets undergoing oxidative stress. PloS one. 7(7):e41345. 2012.
- Wang J, Wang J, Zhang Y. Proteomic analysis of adrenocorticotropic hormone treatment of an infantile spasm model induced by N-methyl-D-aspartic acid and prenatal stress. PloS one. 7(9):e45347. 2012.
- Seyfried NT, Gozal YM, Donovan LE. Quantitative analysis of the detergent-insoluble brain proteome in frontotemporal lobar degeneration using SILAC internal standards. Journal of proteome research. 11(5):2721-38. 2012.
Related Products / Services
Please note: All products are "FOR RESEARCH USE ONLY AND ARE NOT INTENDED FOR DIAGNOSTIC OR THERAPEUTIC USE"
